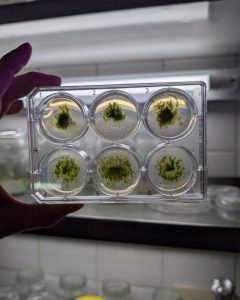

Título del seminario: “Estrategias biotecnológicas para optimizar la producción de alcaloides del tropano en sistemas vegetales: cultivo in vitro y biotransformación”.
Disertante: Bioq. Thomas Di Martino (Becario Doctoral CONICET y estudiante del Doctorado Binacional Milstein-Köhler en Ciencias Biomédicas, Universidad de Buenos Aires - Universidad de Friburgo)
Directora: Dra. Alejandra Cardillo
Codirector: Dr. Julián Rodríguez Talou
Directora en Alemania: Dra. Eva Decker
Lugar de trabajo: Instituto de Nanobiotecnología (NANOBIOTEC UBA-CONICET) y Área de Biotecnología Vegetal, Facultad de Biología, Universidad de Friburgo.
Resumen: Los alcaloides del tropano son metabolitos secundarios producidos principalmente por plantas de la familia Solanaceae, entre los que destacan la hiosciamina, anisodamina y escopolamina por su gran importancia farmacéutica. Debido a su potente actividad anticolinérgica, estos compuestos son considerados medicamentos esenciales; sin embargo, su compleja estructura química dificulta su síntesis a gran escala. Por este motivo, su producción depende casi exclusivamente de cultivos tradicionales, lo que la vuelve vulnerable a factores ambientales y a fluctuaciones globales. En la ruta biosintética de estos alcaloides, la enzima hiosciamina 6β-hidroxilasa (H6H) cumple un rol central al catalizar las dos últimas reacciones que conducen a la formación de escopolamina, convirtiéndose en un blanco estratégico para el desarrollo de enfoques biotecnológicos orientados a mejorar su producción. En este contexto, los sistemas de expresión en plantas han surgido como plataformas prometedoras para la producción a gran escala de productos biológicos, funcionando como biofábricas en el marco del molecular farming. Técnicas como la agroinfiltración en Nicotiana benthamiana permiten una expresión transitoria rápida de proteínas recombinantes, mientras que el musgo Physcomitrella patens ofrece ventajas como la recombinación genética precisa y el cultivo en biorreactores bajo condiciones controladas. El objetivo de esta línea de trabajo es evaluar estas plataformas mediante la expresión de la enzima H6H, con el fin de explorar su potencial para la producción biotecnológica de compuestos de interés farmacéutico. En este seminario se presentarán los avances obtenidos durante la estadía del disertante en la Universidad de Friburgo (Alemania), así como los próximos pasos de la investigación.
Los alcaloides del tropano, como la hiosciamina y la escopolamina, poseen actividad anticolinérgica y son considerados medicinas esenciales por la OMS. Hoy en día, su producción depende principalmente del cultivo de plantas, lo que limita su disponibilidad. En nuestro laboratorio desarrollamos estrategias biotecnológicas para lograr una producción más eficiente, sostenible y competitiva. Para ello exploramos el uso de sistemas de cultivo de raíces in vitro, elicitación, ingeniería genética y biotransformación.
Cooperación Internacional: Thomas compartió los avances logrados durante su estadía en la Universidad de Friburgo, Alemania, en el marco del Doctorado Binacional Milstein-Köhler.
¡Gracias Thomas por compartir tu trabajo con nosotros!
Dirección: Dra. Alejandra Cardillo, Dr. Julián Rodríguez Talou y Dra. Eva Decker.
Lugar de trabajo: Instituto de Nanobiotecnología (NANOBIOTEC UBA-CONICET) & Univ. de Friburgo.